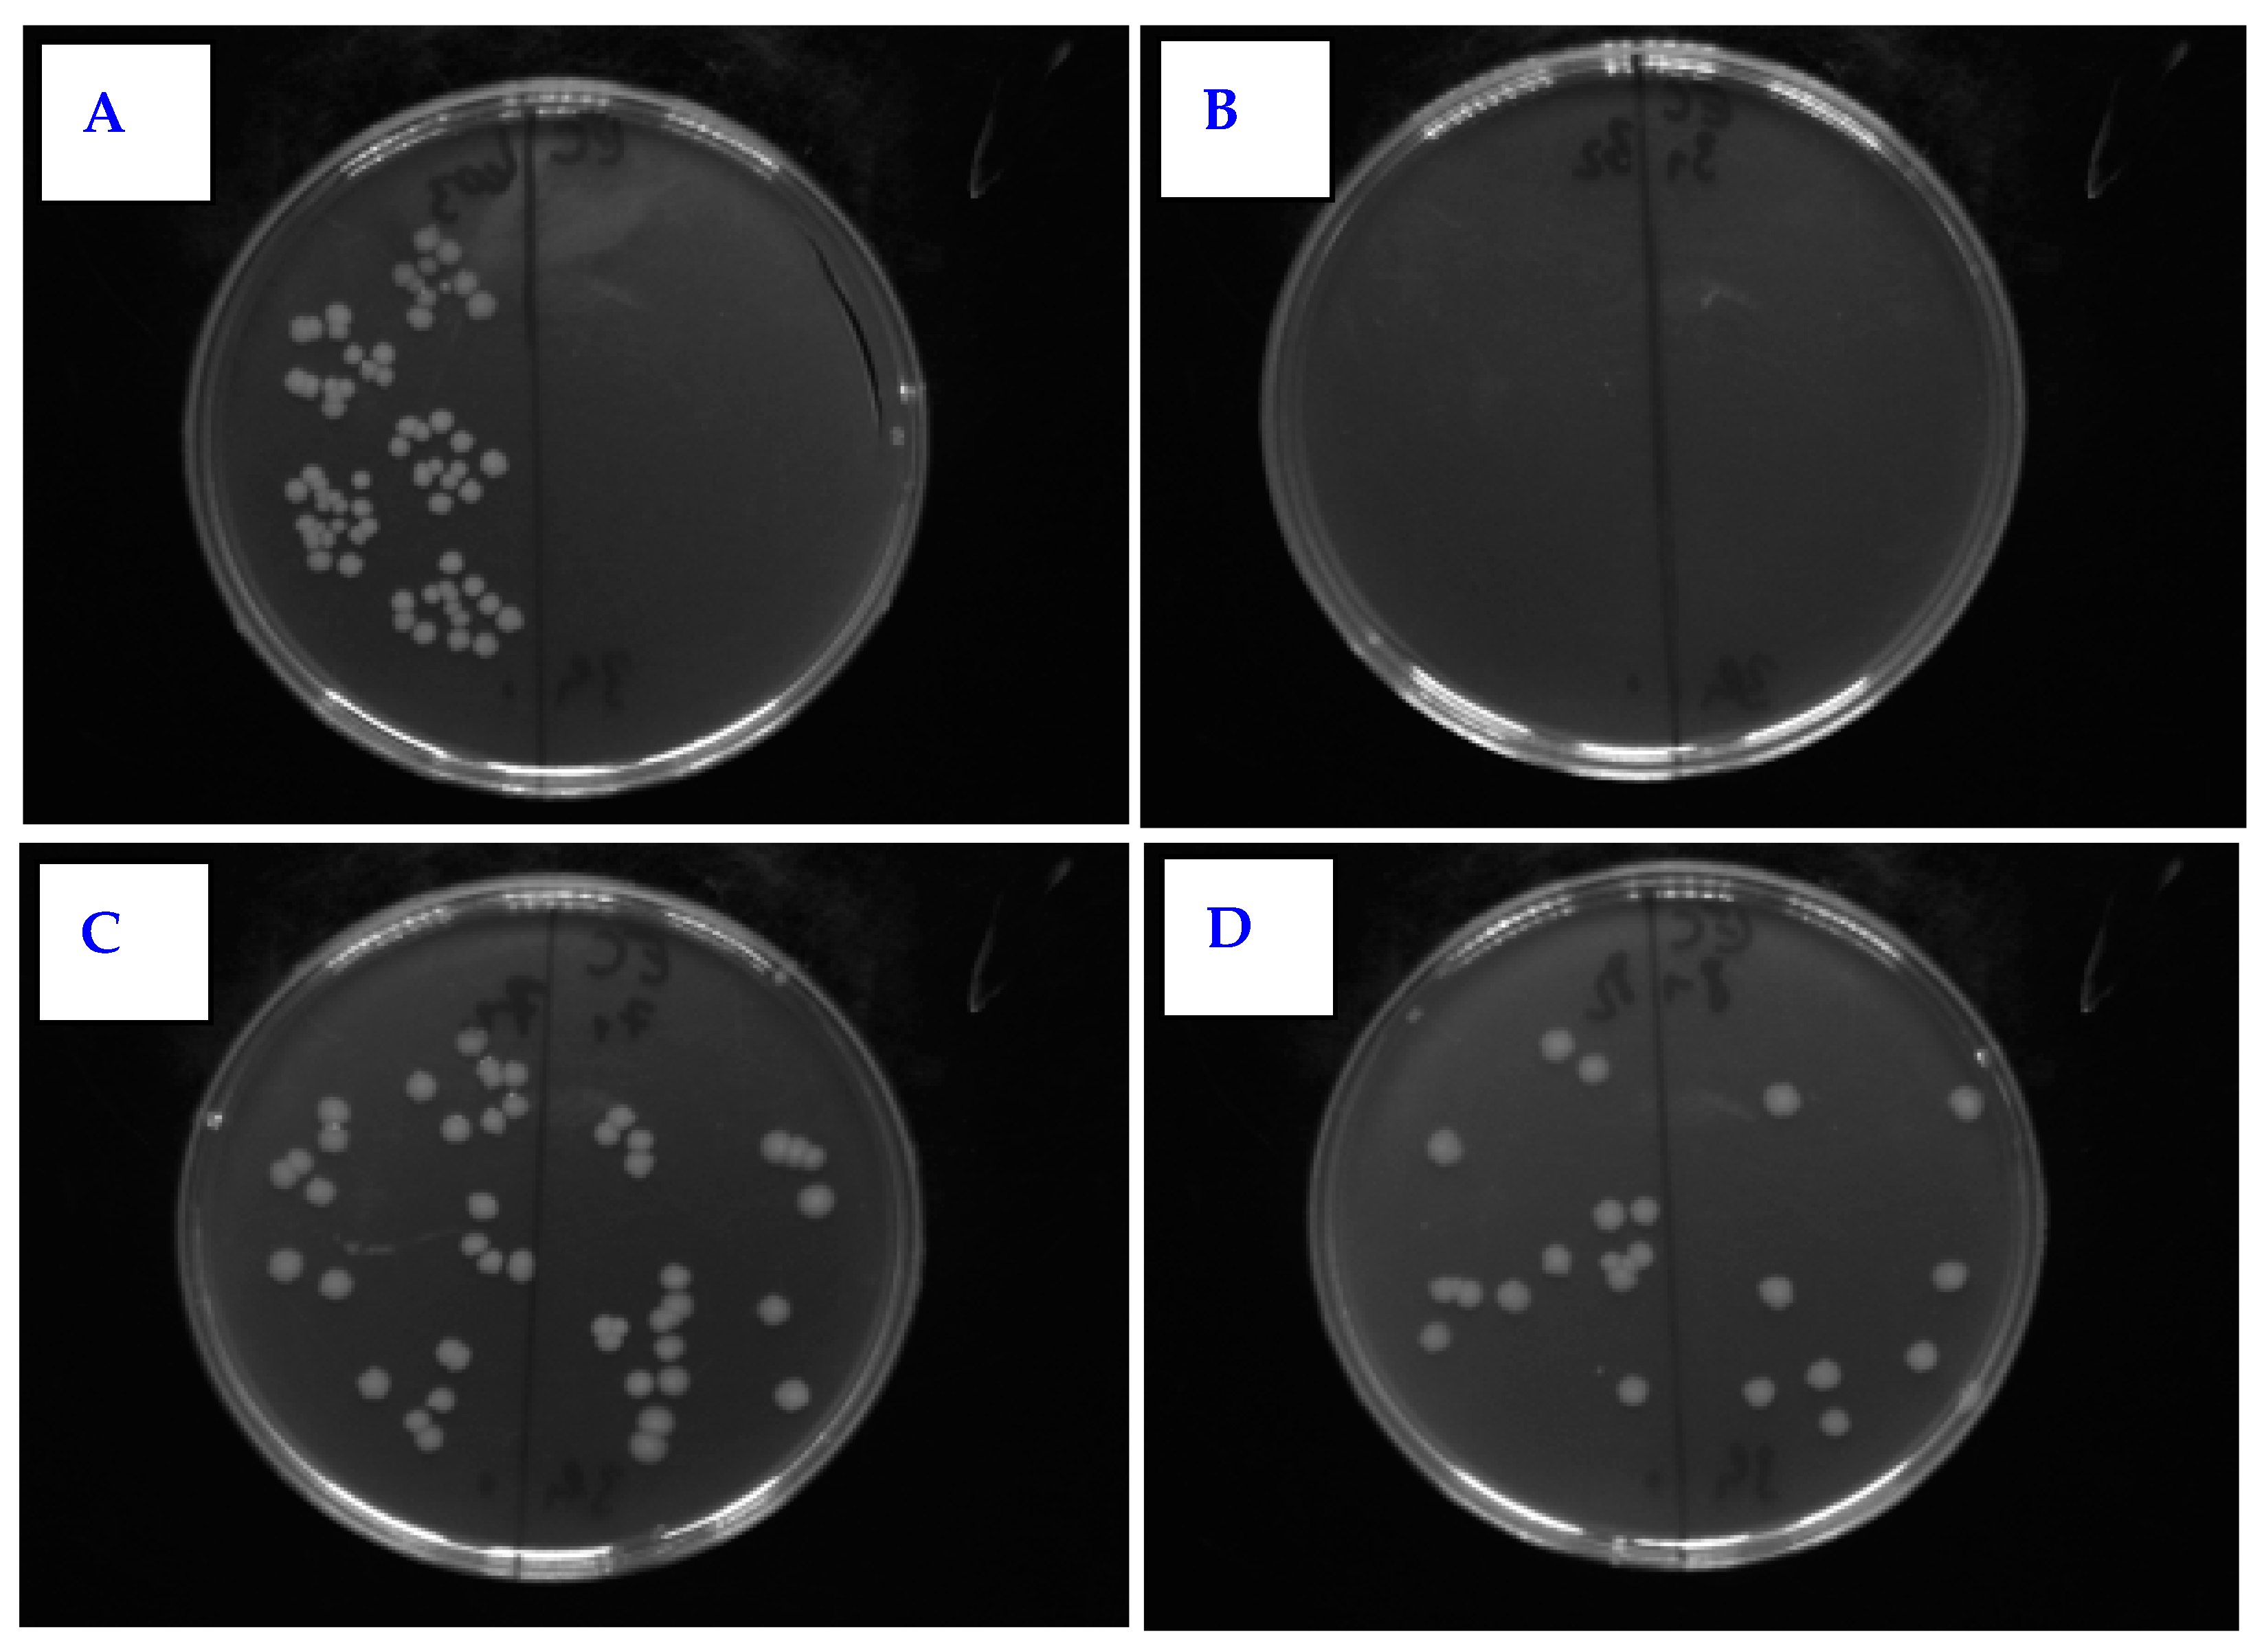
Nanomaterials 11 00182 g017 Nanomaterials 11 00182 g017

Antibacterial Properties of Plasma-Activated Perfluorinated Substrates with Silver Nanoclusters Deposition
Abstract
1. Introduction
2. Materials and Methods
2.1. Materials and Chemicals
2.2. Activation of Substrates
2.3. Characterization of Substrates
2.4. Antibacterial Activity
- pristine PTFE,
- PTFE + Ag 80 s,
- PTFE + Ag 300 s,
- PTFE + plasma 8 W 20 s,
- PTFE + plasma 8 W 240 s,
- PTFE + plasma 8 W 240 s + Ag 80 s,
- PTFE + plasma 8 W 240 s + Ag 300 s,
- PTFE + PLLA,
- PTFE + plasma 8 W 240 s + PLLA,
- PTFE + PLLA + Ag 50 s,
- PTFE + plasma 8 W 240 s + PLLA + Ag 50 s,
- control-physiological solution.
- pristine PFA,
- PFA + Ag 60 s,
- PFA + Ag 240 s,
- PFA + plasma 3 W 240 s,
- PFA + plasma 3 W 240 s + Ag 60 s,
- PFA + plasma 3 W 240 s + Ag 240 s,
- PFA + plasma 8 W 240 s,
- PFA + plasma 8 W 240 s + Ag 60 s,
- PFA + plasma 8 W 240 s + Ag 240 s,
- control-physiological solution.
3. Results
3.1. PTFE and PFA Surface Wettability
3.2. PTFE and PFA Surface Morphology
3.3. Surface Chemistry
3.4. Antibacterial Properties
3.4.1. PTFE
3.4.2. PTFE + PLLA
3.4.3. PFA
4. Conclusions
Supplementary Materials
Author Contributions
Funding
Institutional Review Board Statement
Informed Consent Statement
Data Availability Statement
Conflicts of Interest
References
- Elbourne, A.; Crawford, R.J.; Ivanova, E.P. Nano-structured antimicrobial surfaces: From nature to synthetic analogues. J. Colloid Interface Sci. 2017, 508, 603–616. [Google Scholar] [CrossRef] [PubMed]
- Wang, M.; Tang, T. Surface treatment strategies to combat implant-related infection from the beginning. J. Orthop. Transl. 2019, 17, 42–54. [Google Scholar] [CrossRef] [PubMed]
- Olmo, J.A.-D.; Ruiz-Rubio, L.; Pérez-Alvarez, L.; Sáez-Martínez, V.; Vilas-Vilela, J.L. Antibacterial coatings for improving the performance of biomaterials. Coatings 2020, 10, 139. [Google Scholar] [CrossRef]
- Adlhart, C.; Verran, J.; Azeveda, N.F.; Olmez, H.; Keinänen-Toivola, M.M.; Gouveia, I.; Melo, L.F.; Crijns, F. Surface modifications for antimicrobial effects in the healthcare setting: A critical overview. J. Hosp. Infect. 2018, 99, 239–249. [Google Scholar] [CrossRef] [PubMed]
- Huang, K.; Yang, C.; Huang, S.; Chen, C.; Lu, Y.; Lin, Y. Recent advances in antimicrobial polymers: A mini-review. Int. J. Mol. Sci. 2016, 17, 1578. [Google Scholar] [CrossRef] [PubMed]
- Bazaka, K.; Jacob, M.V.; Chrzanowski, W.; Ostrikov, K. Anti-bacterial surfaces: Natural agents, mechanisms of action, and plasma surface modification. RSC Adv. 2015, 5, 48739–48759. [Google Scholar] [CrossRef]
- Hu, Z.; Chan, W.L.; Szeto, Y.S. Nanocomposite of chitosan and silver oxide and its antibacterial property. J. Appl. Polym. Sci. 2007, 108, 52–56. [Google Scholar] [CrossRef]
- Kumar, N.; Desagani, D.; Chandran, G.; Ghosh, N.N.; Karthikeyan, G.; Waigaonkar, S. Biocompatible agarose-chitosan coated silver nanoparticle composite for soft tissue engineering applications. Artif. Cells Nanomed. Biotechnol. 2017, 46, 637–649. [Google Scholar] [CrossRef]
- Slepička, P.; Slepičková Kasálková, N.; Stránská, E.; Bačáková, L.; Švorčík, V. Surface characterization of plasma treated polymers for applications as biocompatible carriers. Express Polym. Lett. 2013, 7, 535–545. [Google Scholar] [CrossRef]
- Slepička, P.; Peterková, L.; Rimpelová, S.; Pinkner, A.; Slepičková Kasálková, N.; Kolská, Z.; Ruml, T.; Švorčík, V. Plasma activated perfluoroethylenepropylene for cytocompatibility enhancement. Polym. Degrad. Stab. 2016, 130, 277–287. [Google Scholar] [CrossRef]
- Peterková, L.; Rimpelová, S.; Slepička, P.; Slepičková Kasálková, N.; Veselý, M.; Švorčík, V.; Ruml, T. Bioinert fluorinated ethylene-propylene copolymer modified for keratinocyte adhesion. FEBS J. 2016, 283, 318. [Google Scholar]
- Slepička, P.; Neznalová, K.; Fajstavr, D.; Švorčík, V. Nanostructuring of honeycomb-like polystyrene with excimer laser. Prog. Org. Coat. 2020, 145, 105670. [Google Scholar] [CrossRef]
- Neznalová, K.; Sajdl, P.; Švorčík, V.; Slepička, P. Cellulose acetate honeycomb-like pattern created by improved phase separation. Express Polym. Lett. 2020, 14, 1078–1088. [Google Scholar]
- Neznalová, K.; Fajstavr, D.; Rimpelová, S.; Slepičková Kasálková, N.; Kolská, Z.; Švorčík, V.; Slepička, P. Honeycomb-patterned poly(L-lactic) acid on plasma-activated FEP as cell culture scaffold. Polym. Degrad. Stab. 2020, 181, 109370. [Google Scholar] [CrossRef]
- Fajstavrová, K.; Rimpelová, S.; Fajstavr, D.; Švorčík, V.; Slepička, P. PLLA honeycomb-like pattern on fluorinated ethylene propylene as a substrate for fibroblast growth. Polymers 2020, 12, 2436. [Google Scholar] [CrossRef] [PubMed]
- Feng, S.S.; Zhong, Z.X.; Wang, Y.; Xing, W.H.; Drioli, E. Progress and perspectives in PTFE membrane: Preparation, modification, and applications. J. Membr. Sci. 2018, 549, 332–349. [Google Scholar] [CrossRef]
- Kolská, Z.; Řezníčková, A.; Hnatowicz, V.; Švorčík, V. PTFE surface modification by Ar plasma and its characterization. Vacuum 2012, 86, 643–647. [Google Scholar] [CrossRef]
- Zhang, S.; Liang, X.; Gadd, G.M.; Zhao, Q. Advanced titanium dioxide-polytetrafluorethylene (TiO2-PTFE) nanocomposite coatings on stainless steel surfaces with antibacterial and anti-corrosion properties. App. Surf. Sci. 2019, 490, 231–241. [Google Scholar] [CrossRef]
- Yoon, H.J.; Kim, S.E.; Kwon, Y.K.; Kim, E.J.; Lee, J.C.; Lee, Y.S. Synthesis of silver nanostructures on polytetrafluoroethylene (PTFE) using electron beam irradiation for antimicrobacterial effect. J. Ind. Eng. Chem. 2012, 18, 586–590. [Google Scholar] [CrossRef]
- Guo, R.; Yin, G.; Sha, X.; Zhao, Q.; Wei, L.; Wamg, H. The significant adhesion enhancement of Ag–polytetrafluoroethylene antibacterial coatings by using of molecular bridge. Appl. Surf. Sci. 2015, 341, 13–18. [Google Scholar] [CrossRef]
- Akinci, A.; Cobanoglu, E. Coating of Al mould surfaces with polytetrafluoroethylene (PTFE), fluorinated ethylene propylene (FEP), perfluoroalkoxy (PFA) and ethylene-tetrafluoroethylene (ETFE). e-Polymers 2009, 9, 1–7. [Google Scholar] [CrossRef]
- Sprang, N.; Theirich, D.; Engemann, J. Surface modification of fluoropolymers by microwave plasmas: FTIR investigations. Surf. Coat. Technol. 1998, 98, 865–871. [Google Scholar] [CrossRef]
- Zhaia, M.; Gong, Y.; Chena, X.; Xiao, T.; Zhang, G.; Xu, L.; Li, H. Mass-producible hydrophobic perfluoroalkoxy/nano-silver coatings bysuspensionflame spraying for antifouling and dragreduction applications. Surf. Coat. Technol. 2017, 328, 115–120. [Google Scholar] [CrossRef]
- Slepičková Kasálková, N.; Slepička, P.; Kolská, Z.; Hodačová, P.; Kučková, Š.; Švorčík, V. Grafting of bovine serum albumin proteins on plasma-modified polymers for potential application in tissue engineering. Nanoscale Res. Lett. 2014, 9, 161–167. [Google Scholar] [CrossRef] [PubMed]
- Neděla, O.; Slepička, P.; Sajdl, P.; Veselý, M.; Švorčík, V. Surface analysis of ripple pattern on PS and PEN induced with ring-shaped mask due to KrF laser treatment. Surf. Interface Anal. 2017, 49, 25–33. [Google Scholar] [CrossRef]
- Slepicka, P.; Siegel, J.; Lyutakov, O.; Slepickova Kasalkova, N.; Kolska, Z.; Bacakova, L.; Svorcik, V. Polymer nanostructures for bioapplications induced by laser treatment. Biotechnol. Adv. 2018, 36, 839–855. [Google Scholar] [CrossRef] [PubMed]
- Liu, F.; Hashim, N.A.; Liu, Y.; Mhgareg Abed, M.R.; Li, K. Progress in the production and modification of PVDF membranes. J. Membr. Sci. 2011, 375, 1–27. [Google Scholar] [CrossRef]
- Liu, C.; Wu, L.; Zhang, C.; Chen, W.; Luo, S. Surface hydrophilic modification of PVDF membranes by trace amounts of tannin and polyethyleneimine. Appl. Surf. Sci. 2018, 457, 695–704. [Google Scholar] [CrossRef]
- Lim, S.J.; Shin, I.H. Graft copolymerization of GMA and EDMA on PVDF to hydrophilic surface modification by electron beam irradiation. Nucl. Eng. Technol. 2020, 52, 373–380. [Google Scholar] [CrossRef]
- Yavari, M.; Okamoto, Y.; Lin, H. The role of halogens in polychlorotrifluoroethylene (PCTFE) in membrane gas separations. J. Membr. Sci. 2018, 548, 380–389. [Google Scholar] [CrossRef]
- Ebnesajjad, S. Introduction to fluoropolymers. In Applied Plastics Engineering Handbook; William Andrew Publishing: Norwich, UK, 2017; pp. 55–71. [Google Scholar]
- Brobbey, K.J.; Haapanen, J.; Makela, J.M.; Gunell, M.; Eerola, E.; Rosqvist, E.; Peltonen, J.; Saarinen, J.J.; Tuominen, M.; Toivakka, M. Effect of plasma coating on antibacterial activity of silver nanoparticles. Thin Solid Film. 2019, 672, 75–82. [Google Scholar] [CrossRef]
- Okubo, M.; Tahara, M.; Saeki, N.; Yamamoto, T. Surface modification of fluorocarbon polymer films for improved adhesion using atmospheric-pressure nonthermal plasma graft-polymerization. Thin Solid Film. 2008, 516, 6592–6597. [Google Scholar] [CrossRef]
- Tripathi, J.; Sharma, S.; Tripathi, S.; Bisen, R.; Agrawal, L. Modifications in optical and structural properties of PMMA/PCTFE blend films as a function of PCTFE concentration. Mater. Chem. Phys. 2017, 194, 172–181. [Google Scholar] [CrossRef]
- Shan, D.; Grhard, E.; Zhang, C.; Tierney, J.W.; Xie, D.; Liu, Z.; Yang, J. Polymeric biomaterials for biophotonic applications. Bioact. Mater. 2018, 3, 434–445. [Google Scholar] [CrossRef] [PubMed]
- Korzinskas, T.; Jung, O.; Smeets, R.; Stojanovic, S.; Najman, S.; Glenske, K.; Barbeck, M. In vivo analysis of the biocompatibility and macrophage response of a non-resorbable PTFE membrane for guided bone regeneration. Int. J. Mol. Sci. 2018, 19, 2952. [Google Scholar] [CrossRef] [PubMed]
- Abbasian, M.; Massoumi, B.; Mohammad-Rezaei, R.; Samadian, H.; Jaymand, B. Scaffolding polymeric biomaterials: Are naturally occurring biological macromolecules more appropriate for tissue engineering? Int. J. Biol. Macromol. 2019, 134, 673–694. [Google Scholar] [CrossRef] [PubMed]
- Faustino, C.M.C.; Lemos, S.M.C.; Monge, N.; Ribeiro, I.A.C. A scope at antifouling strategies to prevent catheter-associated infections. Adv. Colloid Interface Sci. 2020, 284, 102230. [Google Scholar] [CrossRef]
- Cardoso, V.F.; Correia, D.M.; Ribeiro, C.; Fernandes, M.M.; Lanceros-Méndez, S. Fluorinated polymers as smart materials for advanced biomedical applications. Polymers 2018, 10, 161. [Google Scholar] [CrossRef]
- Dhandayuthapani, B.; Sakthi Kumar, D. Biomaterials for Biomedical Applications; Wiley-VCH Verlag GmbH & Co. KGaA: Weinheim, Germany, 2016; pp. 1–20. [Google Scholar]
- Gomes, M.F.; Amorim, J.B.; Jianassi, L.C.; Castillo Salgado, M.A. Biomaterials for Tissue Engineering Applications in Diabetes Mellitus; InTech: London, UK, 2018. [Google Scholar]
- Shao, H.J.; Chen, C.S.; Lee, I.C.; Wang, J.H.; Young, T.H. Designing a three-dimensional expanded polytetrafluoroethylene-poly(lactic-co-glycolic acid) scaffold for tissue engineering. Artif. Organs 2009, 33, 309–317. [Google Scholar] [CrossRef]
- Banoriya, D.; Purohit, R.; Dwivedi, R.K. Advanced application of polymer based biomaterials. Mater. Today Proc. 2017, 4, 3534–3541. [Google Scholar] [CrossRef]
- Lv, J.; He, B.; Yu, J.; Wang, Y.; Wang, C.; Zhang, S.; Wang, H.; Hu, J.; Zhang, Q.; Cheng, Y. Fluoropolymers for intracellular and in vivo protein delivery. Biomaterials 2018, 182, 167–175. [Google Scholar] [CrossRef] [PubMed]
- Tokiwa, Y.; Calabia, B.P. Biodegradability and biodegradation of poly(lactide). Appl. Microbiol. Biotechnol. 2006, 72, 244–251. [Google Scholar] [CrossRef] [PubMed]
- Sohrabnezhad, S.; Pourahmad, A.; Mehdipour Moghaddam, M.J.; Sadeghi, A. Study of Antibacterial Activity of Ag and Ag2CO3 Nanoparticles Stabilized Over Montmorillonite. Spectrochim. Acta Part A 2015, 136, 1728–1733. [Google Scholar] [CrossRef] [PubMed]
- Lok, C.N.; Ho, C.M.; Chen, R.; He, Q.Y.; Yu, W.Y.; Sun, H.; Tam, P.K.; Chiu, J.F.; Che, C.M. Proteomic analysis of the mode of antibacterial action of silver nanoparticles. J. Proteome Res. 2006, 5, 916–924. [Google Scholar] [CrossRef] [PubMed]
- Feng, Q.L.; Wu, J.; Chen, G.Q.; Cui, F.Z.; Kim, T.N.; Kim, J.Q. A mechanistic study of the antibacterial effect of silver ions on Escherichia coli and Staphylococcus aureus. J. Biomed. Mater. Res. 2000, 52, 662–668. [Google Scholar] [CrossRef]
- Liau, S.Y.; Read, D.C.; Pugh, W.J.; Furr, J.R.; Russell, A.D. Interaction of silver nitrate with readily identifiable groups: Relationship to the antibacterial action of silver ions. Lett. Appl. Microbiol. 1997, 25, 279–283. [Google Scholar] [CrossRef]
- Zhang, X.; Wangband, L.; Levanen, E. Superhydrophobic surfaces for the reduction of bacterial adhesion. RSC Adv. 2013, 3, 12003–12020. [Google Scholar] [CrossRef]

| Ag deposition time [s] | 60 | 80 | 120 | 240 | 300 |
| Thickness [nm] | 3.1 ± 0.1 | 3.5 ± 0.1 | 6.4 ± 0.1 | 9.2 ± 0.2 | 9.8 ± 0.2 |
| Sample | Elemental Concentration (at. %) | |||
|---|---|---|---|---|
| C (1 s) | F (1 s) | O (1 s) | N (1 s) | |
| Pristine PTFE | 32.13 | 67.87 | - | - |
| PTFE + plasma 3 W 60 s | 36.00 | 59.13 | 4.55 | 0.32 |
| PTFE + plasma 3 W 120 s | 37.94 | 56.79 | 4.94 | 0.33 |
| PTFE + plasma 3 W 240 s | 40.46 | 50.80 | 8.38 | 0.36 |
| PTFE + plasma 8 W 60 s | 40.01 | 51.36 | 8.31 | 0.31 |
| PTFE + plasma 8 W 120 s | 40.14 | 50.93 | 8.51 | 0.43 |
| PTFE + plasma 8 W 240 s | 40.02 | 50.93 | 8.69 | 0.36 |
| Sample | Elemental Concentration (at. %) | |||
|---|---|---|---|---|
| C (1s) | F (1s) | O (1s) | N (1s) | |
| Pristine PFA | 29.35 | 70.47 | 0.18 | - |
| PFA + plasma 3 W 60 s | 34.22 | 51.46 | 7.78 | 1.97 |
| PFA + plasma 3 W 120 s | 40.46 | 52.95 | 6.59 | - |
| PFA + plasma 3 W 240 s | 33.02 | 53.30 | 8.23 | 1.48 |
| PFA + plasma 8 W 60 s | 43.19 | 46.41 | 9.90 | 0.51 |
| PFA + plasma 8 W 120 s | 27.64 | 50.75 | 9.26 | 1.88 |
Publisher’s Note: MDPI stays neutral with regard to jurisdictional claims in published maps and institutional affiliations. |
© 2021 by the authors. Licensee MDPI, Basel, Switzerland. This article is an open access article distributed under the terms and conditions of the Creative Commons Attribution (CC BY) license (http://creativecommons.org/licenses/by/4.0/).
Share and Cite
Slepička, P.; Rimpelová, S.; Slepičková Kasálková, N.; Fajstavr, D.; Sajdl, P.; Kolská, Z.; Švorčík, V. Antibacterial Properties of Plasma-Activated Perfluorinated Substrates with Silver Nanoclusters Deposition. Nanomaterials 2021, 11, 182. https://doi.org/10.3390/nano11010182
Slepička P, Rimpelová S, Slepičková Kasálková N, Fajstavr D, Sajdl P, Kolská Z, Švorčík V. Antibacterial Properties of Plasma-Activated Perfluorinated Substrates with Silver Nanoclusters Deposition. Nanomaterials. 2021; 11(1):182. https://doi.org/10.3390/nano11010182
Chicago/Turabian StyleSlepička, Petr, Silvie Rimpelová, Nikola Slepičková Kasálková, Dominik Fajstavr, Petr Sajdl, Zdeňka Kolská, and Václav Švorčík. 2021. "Antibacterial Properties of Plasma-Activated Perfluorinated Substrates with Silver Nanoclusters Deposition" Nanomaterials 11, no. 1: 182. https://doi.org/10.3390/nano11010182
APA StyleSlepička, P., Rimpelová, S., Slepičková Kasálková, N., Fajstavr, D., Sajdl, P., Kolská, Z., & Švorčík, V. (2021). Antibacterial Properties of Plasma-Activated Perfluorinated Substrates with Silver Nanoclusters Deposition. Nanomaterials, 11(1), 182. https://doi.org/10.3390/nano11010182






